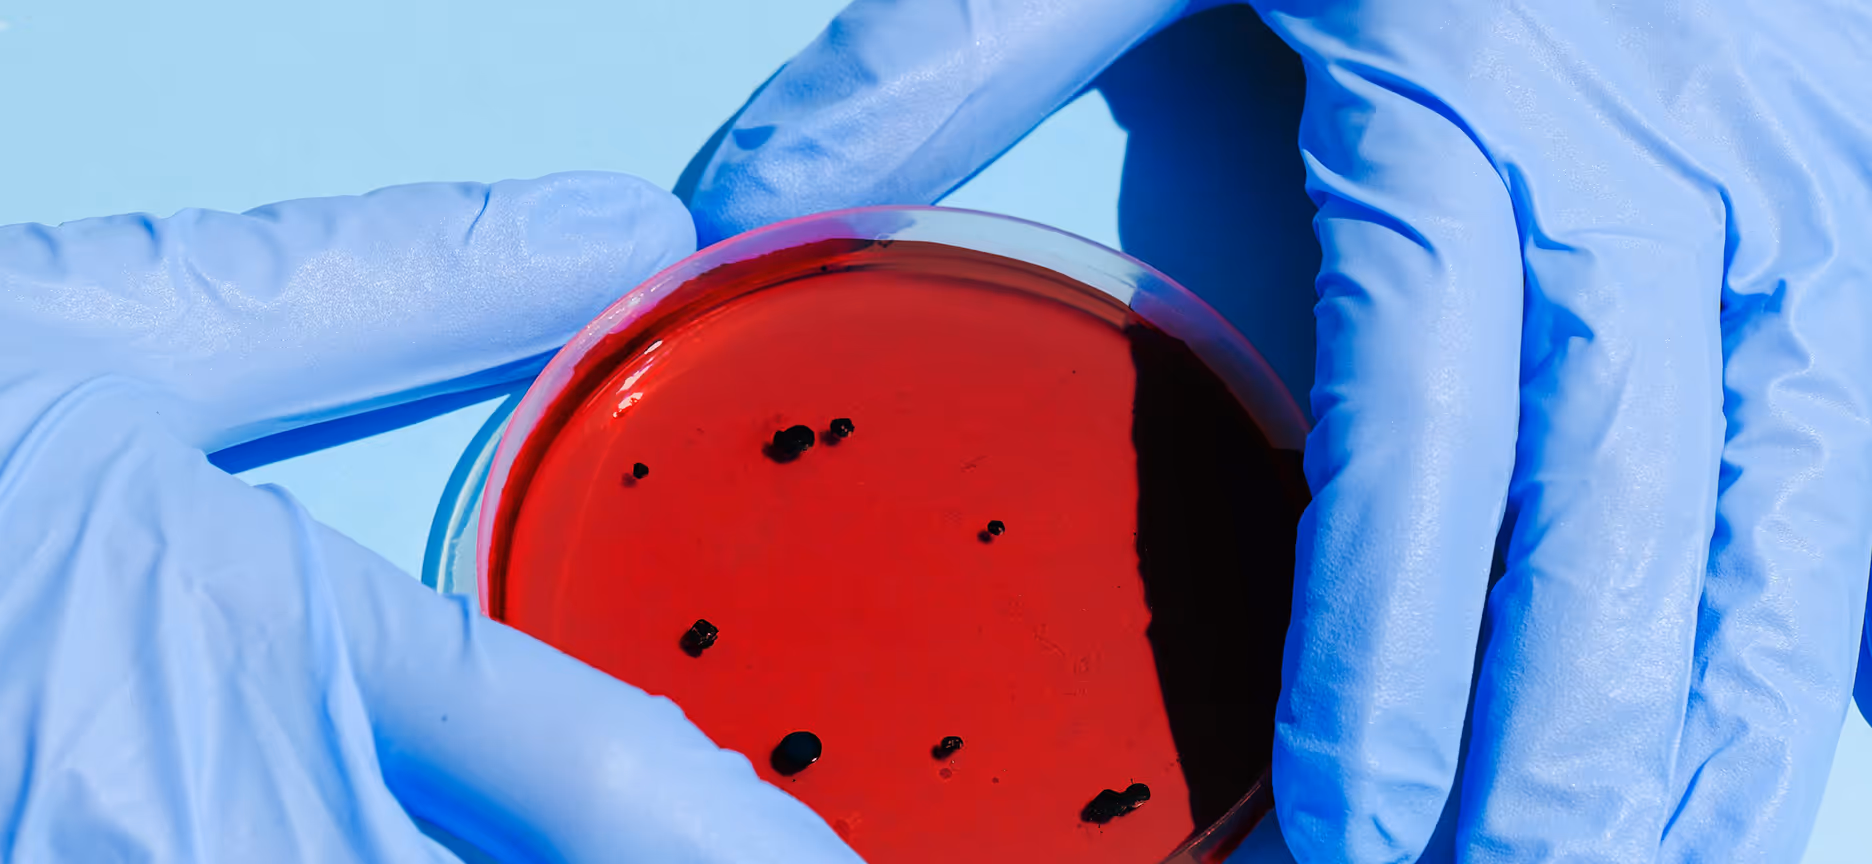

Healthcare Mobile Apps Built for Patients, Architected for AI
We build healthcare mobile applications that patients actually use. Medication adherence tools, remote patient monitoring, telemedicine, clinical mobile solutions, and wearables-connected health apps. Consumer-grade UX with pharmaceutical-grade security, from healthcare app developers who specialize in medical software development.

Built Mobile Health Products for
.svg)

.svg)

.png)

.svg)




.svg)
.svg)

.png)

.svg)




Healthcare Mobile App Development Services
As a health app development company focused exclusively on healthcare, we cover the full spectrum of healthcare application development. From patient-facing engagement tools to provider workflow apps, every project ships with HIPAA-compliant architecture, accessibility standards, and integrations with the clinical systems your users depend on.
Patient Engagement & Adherence Apps
Custom patient app development for medication management and wellness. We build accessible interfaces with advanced notification engines to handle complex dosing schedules and drive long-term patient engagement.
Telemedicine & Remote Care
Telemedicine app development featuring secure video, encrypted messaging, and file sharing. Fully EHR-integrated to provide clinicians with real-time patient context and seamless mobile-to-desktop data synchronization.
Wellness & Sports Apps
Fitness tracking, coaching, and sports performance apps with native wearables integration and health data analytics. We build activity monitoring, workout planning, and gamified engagement powered by multi-device data from our Open Wearables platform.
Wearables-Connected Health Apps
Mobile health apps with multi-device support via our Open Wearables platform. We unify data from Apple Health, Garmin, Oura, and Whoop through a single API that normalizes biometrics across all devices.
Medical Diagnostics & Testing Apps
Secure mobile diagnostic platforms for lab test ordering and result delivery. Features include biometric authentication, intuitive test selection, and clear data visualizations that translate medical results for patients.
Digital Health & Chronic Condition Apps
Digital health apps for chronic disease management and Remote Patient Monitoring (RPM). We enable longitudinal health tracking, care plan adherence, and clinical outcome reporting for both patients and providers.
Healthcare Web Platforms We've Delivered
Our Mobile Tech Stack
We match the stack to the project. Cross-platform when speed and budget matter, native when performance is critical. Every choice is driven by your product requirements, compliance needs, and long-term maintainability.




Frontend Development
Responsive patient portals and clinical interfaces


Backend & APIs
Secure, scalable medical web app architecture


Database & Storage
Healthcare-specific encryption and audit logging


Healthcare Integration
Seamless EHR connectivity and medical data exchange


Security & Compliance
Advanced encryption, OAuth 2.0, and compliant infrasctructure


Why Healthcare Companies Choose Momentum
Healthcare-Only Focus
We are medical mobile app developers who work exclusively in health tech. HIPAA, clinical workflows, wearables APIs, EHR integrations, app store compliance for medical apps. Deep domain knowledge, not a generalist team learning on your project.
AI-Native From the Ground Up
Every mobile app we build is architectured for AI from day one. Health data structured for predictive analytics, recommendation engines, and intelligent clinical features. Powered by our open source tools (Open Wearables, FHIR MCP Server) that make health data AI-ready out of the box.
Compliance From Day One
Security and regulatory compliance from the first commit. Encryption, audit trails, role-based access, and HIPAA-compliant infrastructure. Compliance is how we build, not a checklist at the end.
Proven Patient Scale
1M+ patients served through mobile platforms we built. From early-stage mHealth MVPs to medication management apps used by tens of thousands of seniors, we know what holds up at production scale.
From clinical question to precise answer in seconds
From Discovery to App Store
Discovery & Strategy
We map your clinical workflows, user needs, regulatory requirements, and integration landscape. You get a product roadmap, technical architecture, and compliance plan before a single line of code is written.
Discovery & Strategy
We map your clinical workflows, user needs, regulatory requirements, and integration landscape. You get a product roadmap, technical architecture, and compliance plan before a single line of code is written.
UX/UI Design
Accessible, intuitive interfaces designed for your actual users. We test with real patients, clinicians, and caregivers. Large touch targets, clear typography, and workflows that match how healthcare actually works.
UX/UI Design
Accessible, intuitive interfaces designed for your actual users. We test with real patients, clinicians, and caregivers. Large touch targets, clear typography, and workflows that match how healthcare actually works.
Development & Integration
Cross-platform or native development with continuous integration. EHR connections, wearables data, payment systems, and notification infrastructure built and tested incrementally throughout the project.
Development & Integration
Cross-platform or native development with continuous integration. EHR connections, wearables data, payment systems, and notification infrastructure built and tested incrementally throughout the project.
Compliance & QA
HIPAA security review, penetration testing, accessibility audit, and app store compliance checks. We test across devices, OS versions, and network conditions so your app works in the real world.
Compliance & QA
HIPAA security review, penetration testing, accessibility audit, and app store compliance checks. We test across devices, OS versions, and network conditions so your app works in the real world.
Launch & Ongoing Support
App store submission, monitoring setup, and post-launch optimization. We track user engagement, crash rates, and clinical outcome metrics so you can measure what matters.
Launch & Ongoing Support
App store submission, monitoring setup, and post-launch optimization. We track user engagement, crash rates, and clinical outcome metrics so you can measure what matters.
Our Solutions
Built on Tools We Created
The web platforms we build run on open source infrastructure we maintain. FHIRBoard gives your platform FHIR analytics and visualization. FHIR MCP Server connects applications to clinical data through natural language. HealthStack provisions HIPAA-compliant infrastructure in minutes. Not third-party dependencies. Tools our team built, running in production across our clients' platforms.
Open Wearables
Unified Health API for multi-vendor wearables data integration. Build personal health insights applications without vendor lock-in.

FHIR MCP Server
Natural language AI interface for FHIR servers - query clinical data using conversational prompts instead of complex FHIR queries.

HealthStack
Terraform modules for HIPAA-compliant cloud infrastructure - production-ready AI software for healthcare architecture.

Apple Health MCP Server
AI agents that understand Apple Health data through conversational queries - enabling personal health recommendations.

Notetaker (AI Scribe)
AI-powered medical documentation and clinical note generation - automated transcription with structured FHIR output.

FHIRBoard
Interactive analytics and visualization for FHIR healthcare datasets - transform clinical data into actionable health insights.

Let's Build Your Healthcare Web Platform
Tell us about your project and we'll get back to you within one business day.
.png)
Healthcare Web Application Development FAQ
What types of healthcare app development services does Momentum offer?
We build patient engagement apps, medication adherence tools, telemedicine platforms, remote patient monitoring apps, clinical workflow tools, wearables-connected health apps, and medical diagnostics platforms. Every app ships with HIPAA-compliant architecture and integrations with clinical systems like EHRs and health data APIs.
How do you build a HIPAA compliant mobile app?
We build HIPAA compliance into every mobile project from the architecture level. Encryption at rest and in transit, secure authentication, audit logging, role-based access control, and BAA-ready server infrastructure. Our HealthStack open source modules handle the infrastructure layer so every HIPAA compliant mobile app we ship has compliance built in, not bolted on.
What tech stack do you use for healthcare mobile app development?
We match the stack to the project. Flutter and React Native for cross-platform apps when speed and budget matter. Swift for native iOS app development and Kotlin for Android app development when performance is critical. Backend options include Ruby on Rails, Python, and Node.js. Wearables connect through our Open Wearables platform or direct API integrations with Apple HealthKit, Google Health Connect, Garmin, and others.
Can you build telemedicine and remote care apps?
Yes. We build telemedicine app solutions with secure video, messaging, appointment scheduling, and real-time health data from connected devices. Our telemedicine apps integrate with EHR systems so providers have full clinical context during virtual visits, and with wearables so patients can share health data between appointments.
Do you integrate mobile apps with wearables and health devices?
We connect mobile health apps to data from Apple Health, Garmin, Oura, Whoop, and more. Through our Open Wearables platform, you integrate once and access normalized health data across all supported devices instead of building separate integrations for each vendor.
What is your experience with medical app development for seniors and accessibility?
Our Egis medication management app achieved a 94% ease-of-use rating among senior patients and improved medication adherence by 38%. We design for accessibility from the start: large touch targets, clear typography, intuitive navigation, and reliable notification systems that handle complex medication schedules across different devices and manufacturers.
Do you work with healthcare startups or established companies?
Both. Startups work with us to launch mHealth MVPs with compliance built in from day one. Established healthcare and pharmaceutical companies partner with us for patient engagement apps, digital health companion tools, and clinical mobile solutions. We have delivered mobile platforms serving over 1M patients across 20+ countries.
How do you handle app store requirements for medical and health apps?
We manage the full app store submission process for healthcare apps, including Apple's and Google's specific requirements for medical and health categories. This includes proper content ratings, privacy nutrition labels, health data usage disclosures, and compliance with platform-specific guidelines for apps that handle protected health information.